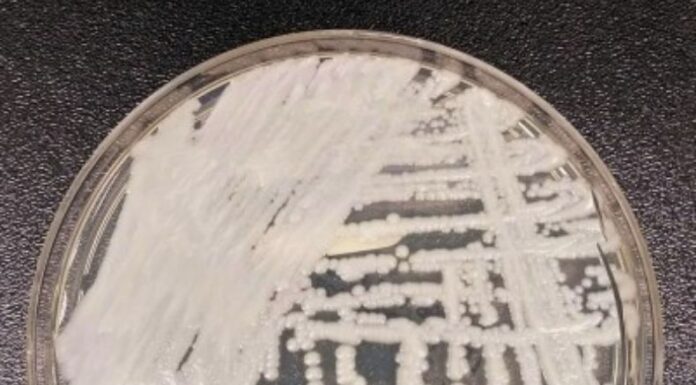

La principal característica que posee la Candida, y por lo cual se está convirtiendo en uno de los hongos más peligrosos, es su resistencia a los medicamentos antifúngicos (contra los hongos), además de que produce, también, infecciones graves en personas con un sistema inmunitario debilitado.
Hasta el momento no se ha emitido ninguna emergencia, sin embargo, en hospitales o centros asistenciales, sí se están tomando las medidas preventivas para evitar que el contagio de personas que permanecen en dichos lugares por diversos motivos.
La sociedad de microbiología, hace un par de días atrás, tuvo un encuentro para tratar sobre el tema de la Candida con un aproximado de 338 delegados de 29 países, incluidos de América del Norte y del Sur, Asia, Australia, África y Europa.
Descubierto en 2009, luego de aislar tras una prueba de oído a un paciente en Japón, se conoce su presencia en países como Estados Unidos, España, Italia, Alemania, India, Sudáfrica y Colombia.
La Organización Mundial de la Salud (OMS), lo ha declarado como 1 de los 19 patógenos más peligrosos, debido a su resistencia a medicamentos y capacidad para sobrevivir en las superficies.
Hasta el momento, en Estados Unidos, ha ido incrementando la cifra contagios. Por ejemplo, para el año 2020, 1,310, pero, en el 2022, la cantidad subió a 5,754 casos. Los especialistas han mencionado que, aunque la cifra (en comparación a la cantidad total del país) puede ser muy baja, la tendencia que llevan es lo que preocupa a muchos médicos.
Síntomas de Candida
Entre las afectaciones que provoca se encuentran:
- Colonizan la piel de una persona sin percibir síntomas- (manchas, erupciones, entre otras)
- Invaden torrente sanguíneo
Además, para las personas que han tenido en algún momento covid-19, o que en este momento se encuentran padeciéndolo, se encuentran más vulnerables a este tipo de contagios de Candida.
Te podría interesar: VIH: el virus que ataca el sistema inmunitario del cuerpo